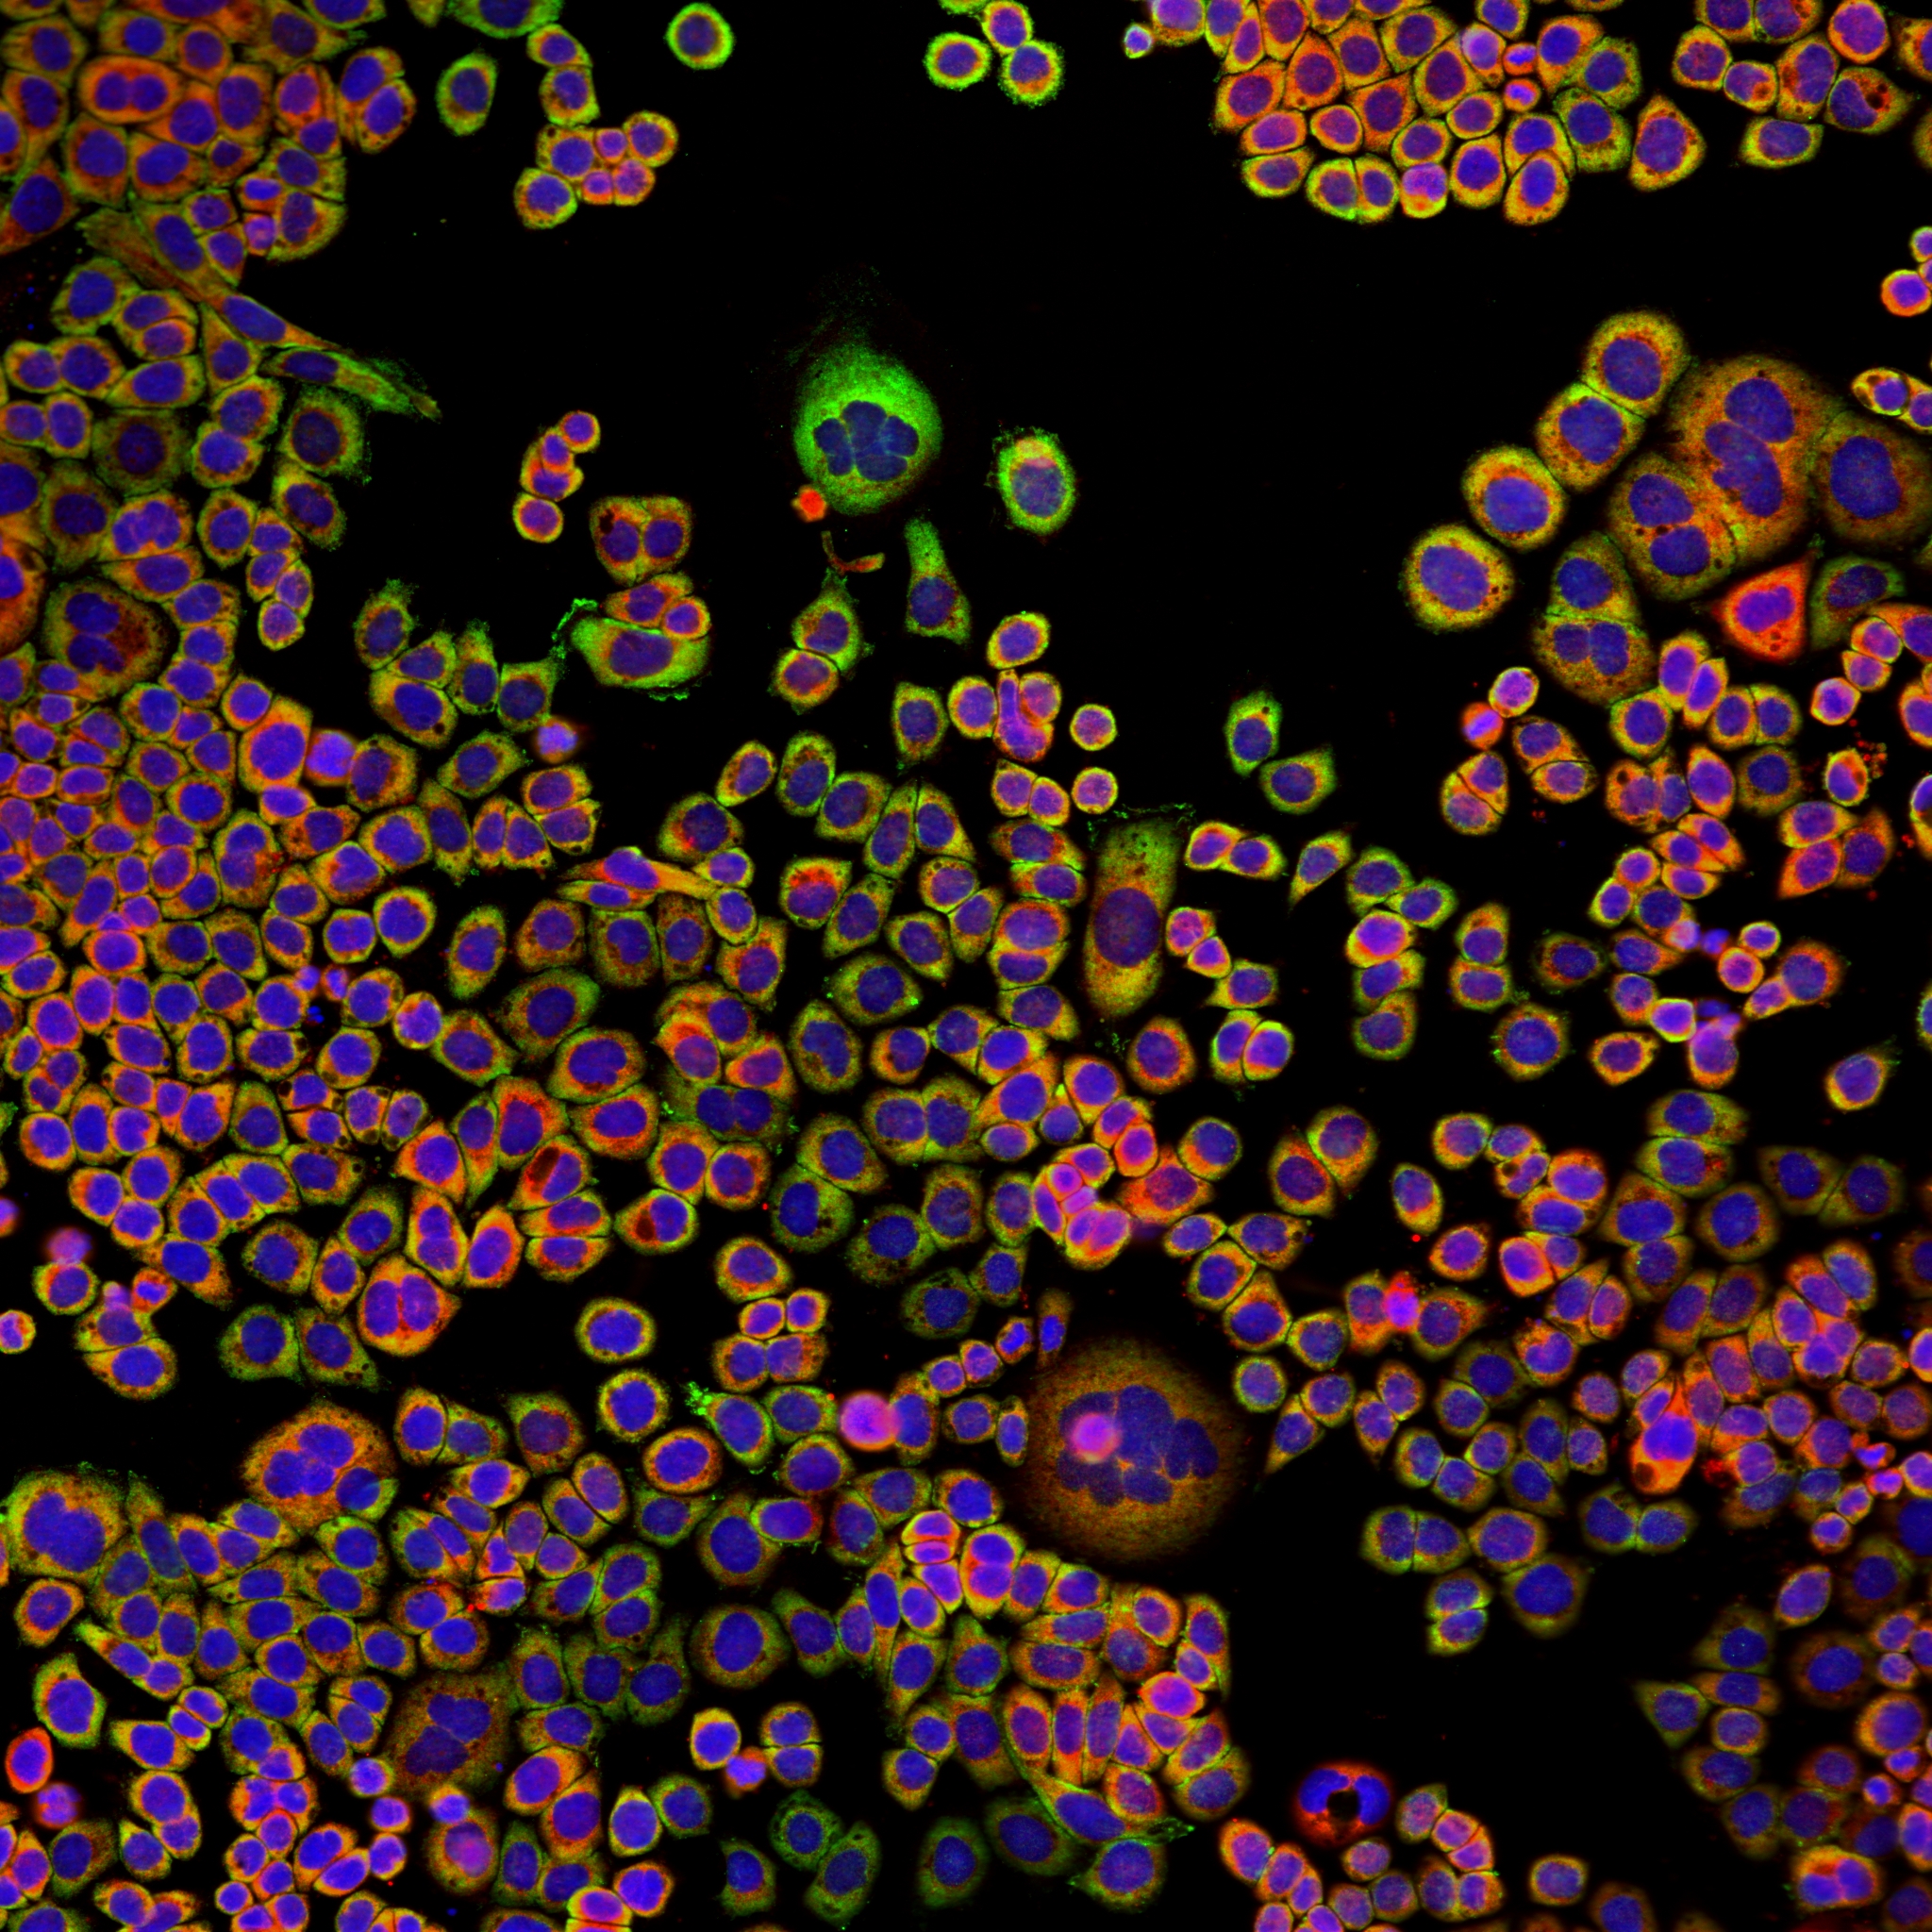

INCA 6000

IN Cell Analyzer 6000 is a highly sensitive, laser-based confocal imaging platform for the most demanding high-content assays and screens. Featuring a novel and proprietary optical system that incorporates an iris-like variable aperture design and next-generation sCMOS technology, IN Cell Analyzer 6000 enables you to optimize for speed and image quality for challenging and variable assays.
Objectives fitted: 10x, 20, 20x (high NA), 40x. Laser lines 405, 488, 561, 640nm) and Transmitted light.
Costs
Price per hour : £50
Price O/N :
Contact details
Facility : Screening Facility
Campus : Blizard (BI)
Address : Blizard Building, 4 Newark Street, Whitechapel, London, E1 2AT
Manager : Luke Gammon
Contact : 020 7882(2342/2404) Or 07985337721